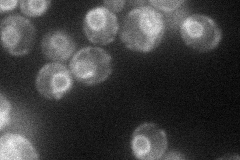
YLR242C
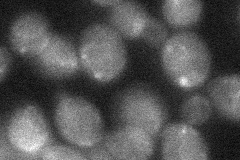
YLR242C

View description
Protein functioning in transport of glycosylphosphatidylinositol intermediates into the ER lumen; required for normal intracellular sterol distribution and for sphingolipid metabolism; similar to Nup120p and C. elegans R05H5.5 protein
Localization:
Intensity:
Fold change:
Significance:
-
C’ GFP library in SD

below threshold16.14 -
N' NOP1pr-GFP in SD
ER48.6369 -
N' TEF2pr-mCherry in SD

ER52.2171 -
N' NATIVEpr-GFP in SD

below threshold16.3427 -
N' TEF2pr-VC and Cyto-VN in SD
below threshold27.536 -
C’ GFP library in SD+DTT

cytosol15.160.93No -
C’ GFP library in SD+H2O2

cytosol16.331.01No -
C’ GFP library in Starvation Media

cytosol16.411.01No -
C’ GFP library on the background of Pup2-DaMP

below threshold -
C’ GFP library on the background of CCT mutant

below threshold16.20121.00322No
